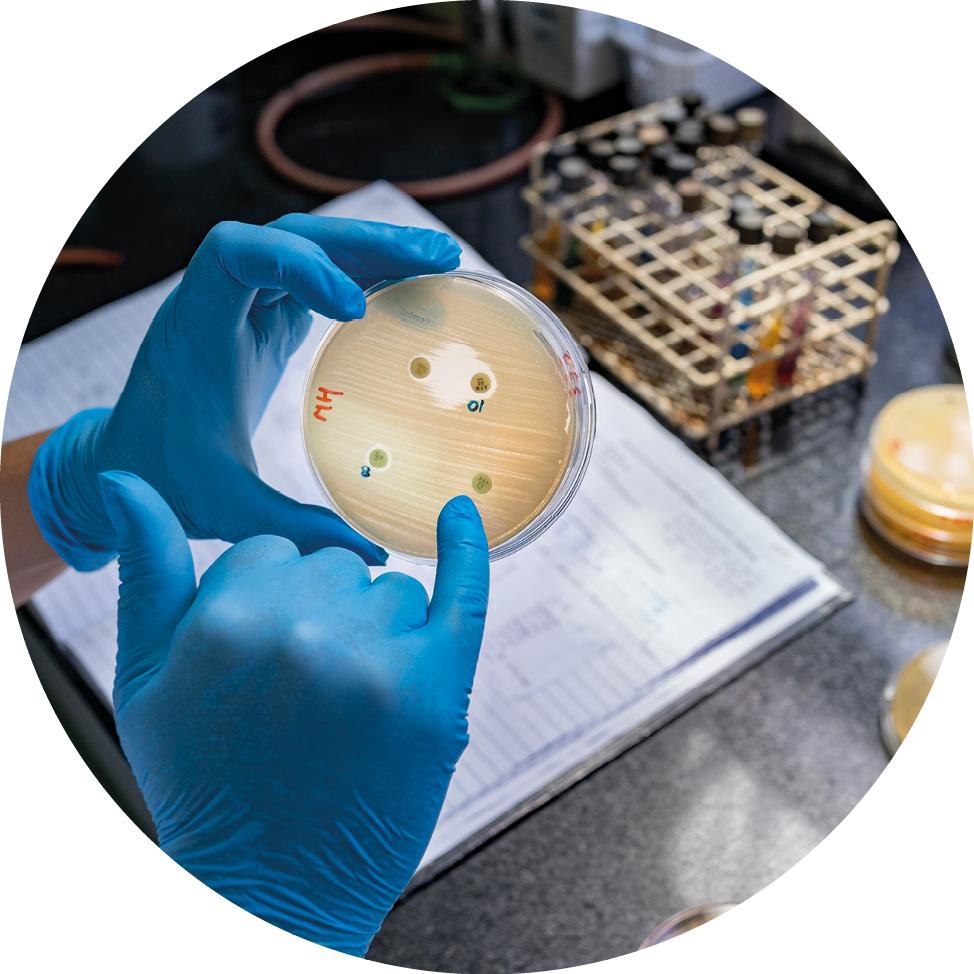
Analyse antimikrobiell resistens, © WHO / Sarah Pabst

2 Prioriteringer

FNs europeiske hovedkvarter i Genève: The Palais des Nations
Foto: UN Photo / Jean-Marc Ferré.
Norge har tre hovedprioriteringer for styreperioden, som omhandler styresett, universell helsedekning, og beredskap og respons i helse- og humanitære kriser.
De tre prioriteringene understøttes av følgende mål:
- Godt styresett: Bedre måten WHO styres og finansieres på. Innsats vil rettes spesielt mot mer effektivt og etterrettelig styresett, bedret organisasjonskultur og mer bærekraftig finansiering, slik at organisasjonen på best mulig måte kan oppnå mål og oppfylle sitt mandat som normativ-, global samhandlings-, utviklings- og humanitær aktør.
- Oppnå universell helsedekning: Styrke WHOs arbeid for bedre nasjonal og internasjonal koordinert og bærekraftig innsats for helsesystemstyrking, som skal sikre rettferdig tilgang til essensielle helsetjenester for alle – uten høy grad av egenbetaling. Særlig oppmerksomhet skal rettes mot forebygging og robuste primærhelsetjenester.
- Bedre beredskap og respons i helse- og humanitære kriser: Norge vil bidra til å styrke globalt arbeid for å forebygge og motvirke utbrudd av infeksjonssykdommer med alvorlige folkehelseimplikasjoner (inkludert pandemier), og sikre tilgang til essensielle helsetjenester i humanitære kriser.

Illustrasjon styresett
Foto: Colourbox

Executive Board Meeting of the World Health Organization
Foto: WHO / Pierre Albouy
2.1 Godt styresett
Norges mål: Bedre måten WHO styres og finansieres på. Innsats vil rettes spesielt mot mer effektivt og etterrettelig styresett, bedret organisasjonskultur og mer bærekraftig finansiering, slik at organisasjonen på best mulig måte kan gjennomføre sine mål og oppfylle sitt mandat som normativ-, global samhandlings-, utviklings- og humanitær aktør.
2.1.1 Bakgrunn
WHO er en medlemslandsstyrt organisasjon med samme prinsipp som andre FN-organisasjoner; hvert land har én stemme. Med støtte fra et sekretariat, utgjør de 194 medlemslandene WHO, og medlemslandene styrer organisasjonen gjennom det øverste beslutningsorganet; Verdens helseforsamling (World Health Assembly (WHA)). Verdens helseministre møtes årlig under helseforsamlingen i Genève for å vedta WHOs strategiske planer, programbudsjetter, resolusjoner og beslutninger. Samlet etablerer dette WHOs mandat, og gir politiske og faglige føringer for arbeidet. WHO har sterk tradisjon for å vedta beslutninger ved konsensus.
WHOs globale styre består av 34 medlemsland, og representerer hver av de seks regionene. Styreplassen er treårig. Styrets hovedoppgave er å legge til rette for helseforsamlingens arbeid og sikre iverksettelse av dens beslutninger. Styremøtene holdes to ganger årlig; i januar/februar og umiddelbart etter helseforsamlingen i mai/juni. Styret kan opprette underliggende komitéer, som eksempelvis program-, budsjett- og administrasjonskomiteen (PBAC) – som Norge leder i perioden juni 2024 til juni 2025.
WHOs sekretariat er organisert på tre nivåer; globalt-, regionalt- og landnivå. Det fireårige arbeidsprogrammet, General Program of Work (GPW), er det overordnede rammeverket for WHOs virksomhet. Programmet danner grunnlag for de toårige budsjettene som behandles av styret og vedtas av helseforsamlingen. Styret informeres om fremgang gjennom interne rapporter fra sekretariatet, inkludert årlige rapporter fra tilsynsorganene, og eksterne evalueringer gjennom blant annet FNs Joint Inspection Unit (JIU) og Multilateral Organisation Performance Assessment Network (MOPAN) 1 .
WHO finansieres delvis av bidrag fra medlemslandene i form av kontingent/pliktige bidrag som blant annet beregnes ut ifra landenes bruttonasjonalprodukt. Nivået besluttes av helseforsamlingen annethvert år. Pliktige bidrag utgjør fleksibel og forutsigbar finansiering, men har over de siste tiårene utgjort under 20 prosent av WHOs totale budsjett. De resterende 80 prosentene finansieres av frivillige, ofte sterkt øremerkede bidrag fra medlemsland, private stiftelser, globale helseinitiativ, fond og øvrige organisasjoner. Finansieringsmodellen gir lav økonomisk forutsigbarhet, store rapporteringsbyrder grunnet mange separate avtaler, samt at for mye tid benyttes på ressursmobilisering. Dette utfordrer WHOs demokratiske grunnprinsipp og organisasjonens rolle som ledende aktør innen global helse.
Som del av FN-systemet og etter initiativ fra WHOs styre, har organisasjonen vært igjennom, og gjennomgår i skrivende stund, flere reformer. Ansvarliggjøring, mer åpenhet, etterlevelse og effektivitet er viktige innsatsområder for bedre styresett. Målet er å bedre ledelse og styring, optimalisere bruk av ressurser, tilrettelegge for bedre resultater og øke tillitt til, samt styrke organisasjonens omdømme. Dette er viktige innsatsområder for Norge.

Møte i Helseforsamlingen i FNs europeiske hovedkvarter
Foto: WHO / Antoine Tardy
2.1.2 Prioriteringer
Mer effektivt og etterrettelig styresett
Som styremedlem vil Norge arbeide for at WHO skal være en effektiv organisasjon med godt omdømme. Norge vil arbeide for at både medlemsland og sekretariatet styrer WHO på en bedre måte. Viktige innsatsområder er å sørge for mer bærekraftig finansiering og støtte pågående reformer som skal bidra til mer åpenhet, ansvarliggjøring, etterrettelighet, bedre risikostyring, tilsynsaktivitet samt at organisasjonen opprettholder etiske standarder. Videre skal Norge bidra til å sikre god økonomi- og ressursstyring samt forebygging av misligheter og korrupsjon.
Som medlem av WHOs styre vil Norge arbeide for å:
- Ansvarliggjøre WHOs medlemsland; gjennom tydeligere forpliktelser til bærekraftig og mer fleksibel finansiering av organisasjon, respekt for prioriteringer vedtatt gjennom arbeidsprogrammet, og tilbakeholdenhet med igangsetting av nye initiativ og resolusjoner. Eksempelvis gjennom å styrke kapasitet på landnivå, blant annet ved forutsigbar ressursdeling til pågående program for å sikre bærekraftig implementering, herunder kontroll og tilsyn.
- Forsterke åpenhet og etterrettelighet i organisasjonens prioriterings- og beslutningsprosesser.
- Bedre intern organisering av fagområder, økt samstemthet mellom finansiering av organisasjon, mål og resultater, samt å unngå siloarbeid.
- Bidra til mer lettfattelig rapportering av sammenhengen mellom ressursbruk og resultater fra organisasjonens tre nivåer.
- Sikre at beslutningen om økning i andelen pliktige bidrag etterleves, samt å bidra til gjennomføring og oppfølging av investeringsrunden – som sammen skal sikre mer bærekraftig finansiering av alle WHOs funksjoner, på tvers av organisasjonen.
- Sørge for at ansvarliggjørring og integritet i tilstrekkelig grad prioriteres på alle tre nivåer i organisasjonen, i tråd med omgivelser og risikobilde.
Bedre organisasjonskultur
Under WHOs ebolarespons i Den Demokratiske Republikken Kongo (mellom 2018 og 2020) ble det avdekket en seksuell overgrepsskandale. Ledelsens håndtering av denne har tydeliggjort behovet for høyere prioritering av risikostyring og helhetlig tilnærming for å sikre etisk praksis på alle organisasjonens nivåer. Det er behov for tiltak for å oppnå kulturendring og en trygg og respektfull arbeidsplass som er fri for utilbørlig atferd. Gode arbeidsforhold er avgjørende for at WHO skal oppnå ønskede resultater. Videre kan tiltak innen dette området redusere omdømmerisiko.
Som medlem av WHOs styre vil Norge arbeide for å:
- Formidle tydelige krav og forventninger til videre styrking av arbeidet med å bygge en tillitsbasert kultur, og forebygge og respondere på seksuell utnyttelse, misbruk og trakassering, samt andre former for utilbørlig atferd; som diskriminering, maktmisbruk, misligheter og korrupsjon.
Bedre organisering av det humanitære arbeidet
WHO er en humanitær aktør. Når det oppstår kriser, må organisasjonen, i samarbeid med partnere, levere raskt og effektivt. I større humanitære kriser etableres «klynge-organisering» på landnivå, som skal sikre god koordinering og hindre gap og overlapp i humanitær respons. Tett koordinering og samarbeid på tvers er en forutsetning for å sikre nødlidende beskyttelse og assistanse.
Som medlem av WHOs styre vil Norge arbeide for å:
- Videreføre Norges humanitære tilnærming ved å fortsette å være en forutsigbar og fleksibel giver, slik at WHO og partnere raskt skal kunne reagere på skiftende humanitære behov.
- Følge WHOs gjennomføring av The Grand Bargin 2 og øvrige reformforpliktelser for effektiv humanitær innsats.
- Monitorere FN-reform om helhetlig innsats og WHOs bidrag for å bedre samspillet mellom humanitær innsats og utviklingspolitikk innen helsesektoren.
Redusere organisasjonens klimaavtrykk
For å nå målet om å begrense klimaendringene, har det internasjonale klimaforskningsmiljøet i stadig sterkere grad påpekt behov for økt innsats innen alle samfunnsområder. Samtidig har effektene av klimaendringer for folkehelse og helsetjenestelevering blitt klarere. WHO har tatt en tydeligere rolle i å understreke sammenhengen mellom klima og helse, og vil fremover innlemme innsats på klima horisontalt i organisasjonen.
Som medlem av WHOs styre vil Norge arbeide for å:
- Analysere klimaavtrykk fra egenaktivitet fra WHOs tre nivåer, for å legge til rette for å redusere aktivitetsrelaterte klimagassutslipp over tid.

Illustrasjon klimaendringer og helse
Foto: Colourbox
2.2 Oppnå universell helsedekning
Norges mål: Styrke WHOs arbeid for bedre koordinert og bærekraftig nasjonal og internasjonal innsats for helsesystemstyrking, som skal sikre rettferdig tilgang til essensielle helsetjenester for alle – uten høy grad av egenbetaling. Særlig oppmerksomhet skal rettes mot forebygging, samt robuste primærhelsetjenester som tilbyr integrerte helsetjenester.
2.2.1 Bakgrunn
Alle mennesker har rett til å oppnå den høyeste mulige standarden for helse. Bærekraftsmål 3.8 om universell helsedekning (UHC) skal innen 2030 sikre tilgang til essensielle helsetjenester av god kvalitet og tilgang til trygge, effektive og rimelige legemidler og vaksiner for alle, med lav grad av egenbetaling for pasientene. Et av de mest grunnleggende argumentene for UHC er den fundamentale retten til helse for alle, noe som også er uunnværlig for å oppnå andre menneskerettigheter 3 .

Helsekontroll
Photo: Colourbox

Møte om forebyggende helse i Kenya
Photo: WHO / Billy Miaron
WHOs definisjon av UHC er at alle mennesker har tilgang til hele spekteret av helsetjenester de trenger (av god kvalitet), når, og der de trenger det – uten å oppleve økonomiske vanskeligheter. Dette inkluderer forebygging, behandling og rehabilitering. Verden ligger ikke an til å nå UHC-målet innen 2030. Fremgang i helsetjenestedekning har stagnert siden 2015, og andelen av verdens befolkning som opplever katastrofale helseutgifter har økt – mye grunnet de økonomiske og helsemessige konsekvensene av covid-19 pandemien 4 .
Alle land må prioritere tilgjengelige ressurser ut fra lokale forhold og behov. Målet bør imidlertid være å realisere retten til helse og oppnå mest mulig helse for alle, ut ifra prinsipper om rettferdighet (equity), åpenhet og inkludering. Den mest effektive måten å oppnå kostnadseffektivitet og rettferdig tilgang på, er gjennom investering i primærhelsetjenester (PHC). Primærhelsetjenesten kan levere 90 % av helsetiltakene som skal til for å oppnå UHC 5 .
Mye av den globale helseinnsatsen de siste 30 årene har vært dreid mot sykdomsspesifikke initiativer. Pandemi og klimakrise har imidlertid understreket behovet for å bygge robuste og helthetlige primærhelsetjenester som kan håndtere den økende globale byrden av ikke-smittsomme sykdommer (NCD) og effekter av klimaendringer. Dette krever samordnet handling globalt, regionalt og nasjonalt, og tiltak på tvers av sektorer (health in all policies). Investeringer i forebyggende tiltak som blant annet reduserer sosial ulikhet i helse og forekomsten av ikke-smittsomme sykdommer, har også positiv innvirkning på lands økonomiske utvikling, og kan redusere presset på helsetjenestene 6 . Særlig effektive tiltak er regulering og særavgifter for helse, spesielt på alkohol og tobakk, supplert med ytterligere forebyggende strukturelle tiltak – spesielt rettet mot unge 7 .
Primærhelsetjenesten må også inkludere kapasiteter og systemer for forebygging, varsling, beredskap og krisehåndtering. For å oppnå dette er det avgjørende at land har tilgang til nok og kvalifisert helsepersonell og etablerer robuste systemer tilpasset ulike kontekster. Særlig blir dette viktig for kriseutsatte land. Lavinntektsland og flere mellominntektsland er de som gjentakende ganger utsettes for komplekse humanitære kriser. Det er også de som har lavest kapasitet i primærhelsetjenesten og begrenset mulighet til å forebygge og håndtere egen befolknings helseutfordringer. En kompliserende faktor er at den økende graden av voldelige kriser stiller helsesektoren, WHO og øvrige internasjonale støttespillere overfor helt spesielle utfordringer. Områder rammet av konflikt er ofte også mest utsatt for klimaendringer og naturkatastrofer, med myndigheter som minst er i stand til å håndtere dette.

Et mobilt helseteam undersøker ernæringsstatus i Kenya

Måling av blodtrykk
Foto: Colourbox

Helsesenter i Rwanda
Foto: WHO / Isaac Rudakubana
2.2.2 Prioriteringer
Bedre koordinert, bærekraftig og land-drevet innsats for universell helsedekning
For å oppnå universell helsedekning vil Norge arbeide spesielt for at primærhelsetjenester prioriteres, med integrering av tjenester som blant annet forebygging og behandling av smittsomme og ikke-smittsomme sykdommer, psykiske plager/lidelser, seksuell- og reproduktiv helse og rettigheter. Primærhelsetjenesten skal videre tåle effekter av klima-, miljø- og naturendringer, som økning i klimarelaterte sykdommer og skader, endringer i type, forekomst og utbredelse av smittsomme sykdommer, samt antimikrobiell resistens.
Norge arbeider for at langsiktig og humanitær bistand koordineres bedre, og at det i voldelige humanitære kriser også arbeides med fred og forsoning. Det er viktig å støtte nasjonal innsats for å oppnå UHC og helhetlig helsesystemstyrking – tilpasset konteksten i det enkelte landet. Norge arbeider for å fremme Lusaka-agendaen for å styrke koordinering blant globale aktører rundt lands planer om UHC.Som medlem av WHOs styre vil Norge:
- Understøtte lands arbeid med å utvikle og implementere integrerte nasjonale helseplaner og budsjetter for å oppnå universell helsedekning. Planene bør utvikles gjennom åpne, inkluderende og rettferdige beslutningsprosesser i tråd med resolusjon WHA77.2 Social participation for universal health coverage, health and wellbeing 8 .
- Styrke WHOs tekniske og normative rolle i å understøtte lands utvikling av en integrert helseplan.
- Arbeide for at globale aktører i større grad koordinerer innsats for å understøtte lands planer og bidrar til å oppnå UHC og helsesystemstyrking, herunder oppfølging av Lusaka-agendaen 9 .
- Fremme tverrsektorielle forebyggende tiltak og integrert tjenestelevering, med vekt på primærhelsetjenester.
- Fremme at essensielle helsetjenester tilbys kostnadsfritt eller til en overkommelig pris til alle. Offentlige finansieringsmodeller bør styrkes, fortrinnsvis gjennom progressive skattesystemer som bidrar til å redusere ulikhet, og delvis gjennom særavgifter for helse.
- Ytre behov for å styrke internasjonale mekanismer for å monitorere og ansvarliggjøre nasjonale myndigheter og andre sentrale aktører, for eksempel gjennom et felles internasjonalt rapporteringssystem for UHC og helsesystemstyrking, samt system for å forebygge korrupsjon.
- Støtte WHOs arbeid med å bygge kunnskap om helsekonsekvenser av klimaendringene og muligheter for tilpasning gjennom mer robuste og motstandsdyktige helsesystemer, samt arbeide for redusert miljøpåvirkning og -utslipp i helsesektoren.
- Sikre at oppmerksomhet rettes mot særlige utfordringer for kriseutsatte land/regioner og at deres stemmer og behov blir inkludert i relevante prosesser.

Helsearbeidere
Photo: Colourbox
Fremme WHOs lederskap og agenda innen helsepersonellfeltet
Realising av retten til helse og bedre dekning av helsetjenester avhenger av nok, kvalifisert og tilgjengelig helsepersonell, som opplever trygge og gode arbeidsforhold og -vilkår. Helsepersonell er også avgjørende for å bygge robuste og klimaresiliente helsesystemer som fungerer under ulike krisesituasjoner. Det er stort underskudd av helsearbeidere globalt, og spesielt i lav- og mellominntektsland. Land i alle utviklingsfaser opplever utfordringer knyttet til blant annet utdanning, ansettelse, plassering, bevaring og ytelse av personell 10 .Som medlem av WHOs styre vil Norge arbeide for å:
Støtte oppunder WHOs globale strategi for helsepersonell (2030) 11 og WHOs (i samarbeid med ILO og OECD) handlingsplan for helse- og omsorgspersonell Working for Health 12 – som verktøy for å styrke helsepersonellagendaen i tråd med resolusjon WHA75.17 Human resources for health 13 . Dette inkluderer blant annet:
- Formidle viktigheten av å optimalisere ressursbruk; fremme tiltak for god styring og ledelse, herunder å planlegge, utdanne, videreutvikle og rekruttere etter behov, gode registre for helsepersonell, tilrettelegge for hensiktsmessig oppgavedeling og kompetansesammensetting (skills mix), samt tiltak for å beholde personell gjennom bl.a. utviklingsmuligheter og gode arbeidsforhold.
- Bidra til at WHOs kode for internasjonal rekruttering av helsepersonell forblir relevant og effektiv.

Ruiner etter Makariv distriktssykehus i Ukraina
Foto: WHO / Christopher Black

Forskningslaboratorie
Photo: Colourbox
Styrke WHOs rolle i å øke tilgang til essensielle legemidler og vaksiner
Land står overfor en rekke hinder i oppnåelsen av universell tilgang til trygge og effektive legemidler av god kvalitet. Situasjonen er kompleks, men de fleste land opplever utfordringer med manglende tilgang, som blant annet bunner i sårbarheter og avhengigheter i globale verdikjeder og høye priser. I tillegg er farene ved og økende grad av forfalskede legemidler i forsyningskjedene en stor utfordring i mange land 14 .
Som medlem av WHOs styre vil Norge:
- Støtte WHOs arbeid for å sikre tilgang til essensielle legemidler og andre helseprodukter i alle land.
- Støtte oppunder implementeringen av resolusjon WHA72/8: Improving the transparency of markets for medicines, vaccines, and other health products 15 .
- Overføre erfaringene fra Oslo Medicines Initiative (OMI) til WHO globalt, knyttet til måling av tilgang til legemidler, felles forhandlinger/innkjøp og økt transparens.
- Styrke innsats for lokal og regional produksjon av legemidler og WHOs rolle i regulatoriske systemer for legemidler, herunder vaksiner og andre helseprodukter.
2.3 Bedre beredskap og respons for helse- og humanitære kriser
Norges mål: Norge vil bidra til å styrke globalt arbeid for å forebygge og motvirke utbrudd av infeksjonssykdommer med alvorlige folkehelseimplikasjoner (inkludert pandemier), og sikre tilgang til essensielle helsetjenester i humanitære kriser.
2.3.1 Bakgrunn
Koronapandemien viste tydelig en felles global sårbarhet overfor pandemier og et klart behov for internasjonalt samarbeid. Klimaendringer, urbanisering, økende antimikrobiell resistens og en rekke andre faktorer øker risikoen for nye pandemier.
Ansvaret for å ivareta nasjonal helseberedskap ligger hos nasjonale myndigheter. Landene er likevel avhengig av forhold i andre land, vilje til multilateralt samarbeid, internasjonale systemer, og av globale fellesgoder. Det globale aktørlandskapet for helseberedskap er mangfoldig. Med sin normative, ledende og koordinerende rolle er WHO avgjørende for at verden skal ha god kunnskap, og for at landene, WHO og andre aktører innenfor sine respektive mandater skal kunne forebygge og håndtere helsekriser mest mulig effektivt og koordinert.
WHO har en viktig operasjonell rolle i helsekriser og øvrige humanitære kriser. Det er stort behov for å styrke lands og verdenssamfunnets evne til å forebygge og håndtere utbrudd av smittsomme sykdommer for å unngå framtidige pandemier. Når helsekriser oppstår, er den vanlige helsetjenesten ansvarlig for håndteringen. Gode folkehelsefunksjoner, en solid helsetjeneste og helsemyndigheter som har samfunnets tillit, er sentralt for lands helseberedskap. I stortingsmeldingen En motstandsdyktig helseberedskap – fra pandemi til krig i Europa 16 , gis politisk og strategisk retning for norsk helseberedskap. Norge har som generell tilnærming at styrking av helseberedskap ses som en integrert del av øvrig helsesystemstyrking og forbedring av styresett på landnivå.
Samtidig med økt risiko for pandemier, har de humanitære behovene økt dramatisk siste tiår. FN anslår nå at rundt en fjerdedel av verdens befolkning lever i konfliktrammede områder. FNs høykommissær for flyktninger anslår at 130 millioner mennesker blir tvunget på flukt i eget land eller over landegrensene i 2024. Dette skjerper også kravene til helseberedskap og respons mot helsekriser, samt understreker viktigheten av å etablere robuste helsetjenester som kan omstilles til å håndtere ulike former for kriser. Å forebygge og være beredt på helsekriser samt håndtere helsekonsekvensene i komplekse humanitære kriser, er en viktig norsk prioritet. Både akutte og langvarige helsekriser har blitt mer komplekse, og kan ha brede sosiale, økonomiske og utviklingsmessige konsekvenser. Også i humanitære kriser har landets myndigheter og helsesektoren et hovedansvar, men ofte med betydelig støtte fra det internasjonale samfunnet.
Norsk humanitær politikk er en sentral del av utenrikspolitikken, og handler om å redde liv, lindre nød og ivareta menneskers verdighet og rettigheter i humanitære kriser 17 . Dette gjøres gjennom nødhjelp, og ulike tiltak for å beskytte mennesker rammet av kriser. Helse i kriser, inkludert helsekriser, er en sentral del av dette. WHO er en viktig partner i slike kriser, og spiller en sentral rolle gjennom sin normative funksjon og arbeid med andre utviklings- og humanitære aktører. Norge vil under styreperioden arbeide for at WHOs humanitære innsats er helhetlig, og vektlegger effektiv forebygging, varsling, beredskap og krisehåndtering i egen organisasjon, samt overfor landene de bistår.

Helsepersonell med beskyttelsesutstyr
Foto: Colourbox
2.3.2 Prioriteringer
Styrke samarbeid om global helseberedskap og helsesikkerhet
Covid-19 pandemien viste at eksisterende internasjonal koordinering av aktører i helsekriser ikke var god nok, også når det gjelder tilgang til medisinske mottiltak. For å sammen styrke global helseberedskap og helsesikkerhet, må alle lands evne til å bekjempe pandemier og utbrudd av smittsomme sykdommer styrkes. Som et resultat av dette, ble flere prosesser igangsatt i kjølvannet av koronapandemien. Blant annet ble Pandemifondet etablert for å bedre medlemslandenes tilgang til finansiell støtte til forebygging, beredskap og respons til pandemier. I Det internasjonale helsereglementet (IHR) fra 2005 har medlemslandene nedfelt bindende regler for hvordan de og WHO sammen skal hindre spredning av sykdom på tvers av landegrenser. Etter omfattende forhandlinger vedtok helseforsamlingen i 2024 justeringer av IHR-regelverket. Forhandlingene foregikk parallelt med forhandlinger om en ny pandemiavtale, der landene i skrivende stund ikke har kommet til enighet.
For Norge er det viktig å støtte denne innsatsen for å styrke pandemiforebygging, beredskap og respons. Dette inkluderer medlemslandenes evne til å forebygge, oppdage, varsle og bekjempe smittsomme sykdommer før de utvikler seg til pandemier – samt å sikre mer rettferdig tilgang til medisinske mottiltak under pandemier. Videre er dette avgjørende for å forbedre WHOs evne til å støtte sine medlemsland, i samarbeid med andre relevante aktører. Å bruke erfaringene fra The Access to Covid-19 Tools Accelerator, som ble ledet av Norge og Sør-Afrika under Covid-19, er en del av prosessen.

Vaksinering
Foto: Colourbox
Som medlem av WHOs styre vil Norge:
- Være en pådriver for sluttføring av forhandlingene om pandemiavtalen, samt at det etableres gode ordninger for gjensidig ansvarliggjøring for implementeringen av denne og av IHR.
- Arbeide for at erfaringene fra covid-19-pandemien brukes for å styrke internasjonalt samarbeid og koordinering av helseberedskap og kriserespons, med WHO og relevante globale helseaktører, sivilt samfunn, privat sektor og andre aktører. Norge vil understøtte prosesser for en plattform for medisinske mottiltak der WHO har en sentral rolle.
- Understøtte WHOs evne til å innfri sitt mandat, og arbeide for at organisasjonen bidrar til best mulig koordinering i det globale landskapet av relevante aktører, jamfør Lusaka-agendaen. Norge skal føre en samstemt politikk for global helse og helseberedskap på tvers av arenaer.
Styrke En-helse-perspektivet
Klimaendringer, urbanisering, befolkningsvekst, reising og økt global migrasjon er blant faktorene som både fører til at utbrudd og spredning av smittsomme sykdommer med pandemisk potensial blir stadig mer sannsynlig, og at befolkningen blir mer sårbar. De mest sannsynlige pandemier har sitt opphav i samspill mellom mennesker og dyr. For å overvåke potensielle pandemiske trusler og forebygge utbrudd er En-helse-samarbeid på tvers av humanhelse-, veterinær- og miljøsektoren avgjørende. Det er nødvendig med samarbeid om integrert overvåkning, kunnskapsdeling og normativt arbeid. WHO, FNs organisasjon for ernæring og landbruk (FAO), Verdens dyrehelseorganisasjon (WOAH) og FNs miljøprogram (UNEP) har etablert et sentralt firepartssamarbeid for dette.
Som medlem av WHOs styre vil Norge:
- Være pådriver for at En-helse-perspektivet integreres på alle nivåer i samfunnet, og at det skal anses som en del av en tverrsektoriell strategi. Dette er viktig for bedre forebygging og overvåkning av potensielt pandemiske sykdommer.
Intensivere innsats mot antimikrobiell resistens
En-helse-tilnærmingen er avgjørende for å håndtere antimikrobiell resistens (AMR). AMR er ikke lenger en såkalt «stille pandemi», men krever årlig millioner av liv – og trusselen er økende. Det er umiddelbart behov for å styrke infeksjonsforebygging og forebygging av antibiotikaresistens. Viktige innsatsområder er smittevern i helsetjenesten (Infection Prevention and Control (IPC)), rent vann, gode sanitær- og hygieneforhold (WASH), god tilgang til nødvendige antibiotika, mer forsvarlig bruk av legemidler for mennesker og dyr, redusere bruk av plantevernmidler som fremmer resistens, utvikling og tilgjengeliggjøring av vaksiner, samt utvikling av nye antimikrobielle legemidler. Det er et stort globalt behov for kompetanseheving i helsetjenesten og forsvarlig praksis, i tillegg til forbedret tilgang til effektive antimikrobielle legemidler. Dette gjelder særlig i lav- og middelinntektsland. Høynivåmøtet om AMR i FNs generalforsamling som fant sted i 2024, resulterte i en deklarasjon med mål og anbefalte tiltak for medlemsland og for organisasjonene som inngår i firepartssamarbeidet, inkludert WHO.
Som medlem av WHOs styre vil Norge:
- Støtte arbeidet for å begrense utbredelse av AMR gjennom styrket forebygging, forsvarlig bruk av antibiotika og gjennom innovasjon, i tillegg til forbedret global tilgang til antibiotika og gjensidig ansvarliggjøring for implementering av strategier.
Analyse antimikrobiell resistens
Foto: WHO / Sarah Pabst
Øke kunnskap om ikke-farmakologiske tiltak globalt
For å avgrense utbrudd av smittsomme sykdommer, er det nødvendig med god kunnskap om effekten av ikke-farmakologiske smitteverntiltak. Inngripende tiltak som krav til avstand mellom personer i arbeidslivet og på fritid, stengninger av skoler og barnehager, serveringssteder og kulturarrangementer, stengning eller regulering av grensepasseringer og andre former for nedstengning av samfunnet, kan være effektive og nødvendige for å begrense spredning. Dette gjelder særlig mot sykdommer der farmakologiske mottiltak ennå ikke finnes, eller ikke er effektive nok. Slike tiltak kan imidlertid ha store negative konsekvenser. Kunnskapsgrunnlaget om positive og negative konsekvenser av slike tiltak er svakt. Å styrke dette kunnskapsgrunnlaget er sentralt for å kunne håndtere utbrudd med minst mulig negative konsekvenser for samfunnet, og for å skape tillit til myndighetenes håndtering.
Som medlem av WHOs styre vil Norge:
- fortsette å lede an i arbeidet for å styrke kunnskap om ikke-farmakologiske smitteverntiltak og bidra til at WHO, som normativ aktør, tar et særlig ansvar.
Støtte WHOs humanitære innsats
I humanitære situasjoner er krisens karakter avgjørende for hvordan nasjonal og internasjonal humanitær innsats organiseres og følges opp. WHO har et særlig ansvar knyttet til oppfølging av globale, regionale og lokale helsekriser, i tillegg til helsetjenester i ulike humanitære kriser. All humanitær innsats er rettighetsbasert. WHO skal gjennom egne partnere og i koordinering med øvrige tilby ulike former for krisehelsetjenester med oppmerksomhet rettet mot særlig sårbare grupper og deres behov. I tillegg har WHO et viktig pådriveransvar overfor myndigheter og parter i konflikt, ved å påpeke deres forpliktelser til å beskytte sivilbefolkning, pasienter og helsepersonell. WHO er en viktig stemme ved å påpeke brudd på internasjonal humanitærrett ved angrep på helseinstitusjoner. Norge gjør det samme gjennom ulike kanaler for humanitært diplomati.
Som medlem av WHOs styre vil Norge:
- Aktivt støtte WHOs pådriverarbeid for beskyttelse av humanitærretten i situasjoner med voldelige angrep på helsefasiliteter, helsepersonell og pasienter 18 .
- Sikre tilstrekkelig politisk støtte og ressurser til at livreddende helsetjenester forblir en sentral del av WHOs humanitære innsats, og at det i akutte kriser gis rask og effektiv respons, i henhold til WHOs Health Emergency Programme (WHE), ulike nødhjelpsappeller og etablerte ledelsessystem for kriser.
- Understøtte WHO og partneres behov for humanitær tilgang til nødlidende i visse og særlig voldelige kriser.
- Sikre at tematikker som seksuell- og reproduktiv helse og rettigheter, psykisk helse og psykososial støtte gis prioritet i humanitære kriser og som del av langsiktig utviklingsinnsats.
- Sikre at helsetjenestetilbudet særlig ivaretar behov for marginaliserte og ekstra sårbare grupper i humanitære kriser; flyktninger/internt fordrevne, barn/ungdom, kvinner, eldre, personer med funksjonsnedsettelse og minoriteter.
- Sikre at overlevende etter seksualisert og kjønnsbasert vold, uavhengig av kjønn, prioriteres under og etter humanitære kriser – herunder bekjempelse av stigma og diskriminering.
- Følge WHOs rolle på landnivå, gjennom rapporter og resolusjonsforhandlinger om spesifikke humanitære kriser. I tilfeller med komplekse landsituasjoner, skal norske utenrikspolitiske hensyn ivaretas.